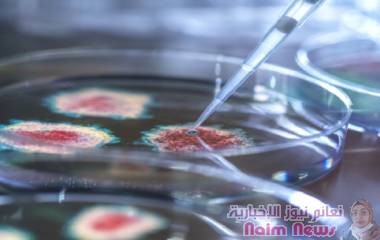
العلماء يعتقدون أن البشر نقلوا الفيروسات إلى الحيوانات أكثر مما يعتقد فعلا!

مشاركات وتطبيقات متعلقة بالوسم فيروس - الصفحة 3
مشاركات وتطبيقات متعلقة بالوسم فيروس - الصفحة 3 الصفحة 3 استعرض كافة المشاركات والتطبيقات المتعلقة بالوسم فيروس
كُشف عن أوميكرون XE كأحدث نوع من متحوّرات فيروس كورونا...
وقال معد الدراسة غريغوري ألبيري، من قسم علم الأحياء...
وقال معد الدراسة غريغوري ألبيري، من قسم علم الأحياء...
شبوة سبأ دشنت اليوم بمحافظة شبوة فعاليات الجولة الثانية...
سجلت ملاوي أول تفش لشلل الأطفال في قارة إفريقيا منذ...
وجدت دراسة أجريت على مستوى الولايات المتحدة أن الرجال...
أعلن تحالف فايرز/بايونتيك أنه بدأ استقبال متطوّعين،...
يعتبر سرطان الكبد أكثر شيوعا عند الرجال فوق سن الستين....
شبوة سبأ افتتح وكيلا محافظة شبوة الدكتور عبدالقوي...
وجد الأطباء أن أقنعة الوجه القماشية لا توفر حماية...
أقرت هيئة تنظيم الأدوية في الاتحاد الأوروبي يوم الاثنين...
قالت الجمعية الألمانية لأبحاث السرطان إن سرطان عنق...